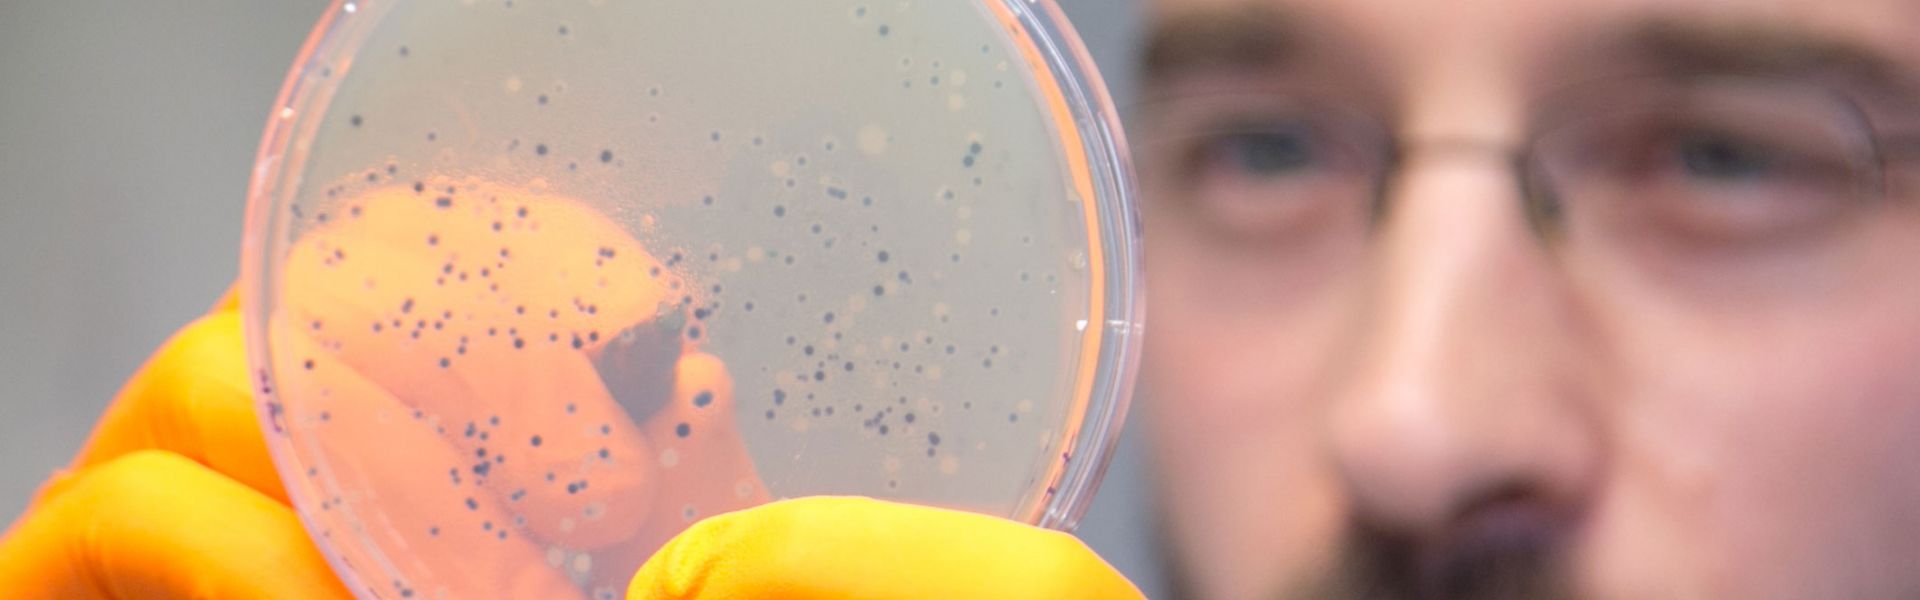

Le laboratoire de santé animale de Maisons-Alfort fête ses 115 ans
Créé en 1901, le Laboratoire de santé animale de Maisons-Alfort, l’un des plus anciens laboratoires au monde spécialisés dans l’étude des maladies infectieuses animales, fête cette année ses 115 ans. Cet événement, intégré aux manifestations des 250 ans de l’Ecole nationale vétérinaire d’Alfort, est l’occasion de dresser un bilan de ses nombreuses années de productions scientifiques et d’expertise, durant lesquelles il a su s’adapter aux avancées technologiques exponentielles de la recherche en biologie, et qui ont fait de lui une référence à travers le monde. C’est aussi le moment de rendre hommage à ses fondateurs, qui ont marqué l’infectiologie vétérinaire, en particulier Edmond Nocard et Emile Roux. Cet anniversaire est également l’opportunité de réfléchir à la place qu’il occupe et continuera d’occuper au service de la surveillance et de la maîtrise des maladies infectieuses animales émergentes et ré-émergentes, en relation avec la santé humaine, à l’aune des bouleversements climatiques, écologiques et socio-économiques que connaît notre planète.
Le Laboratoire de santé animale de Maisons-Alfort doit faire face aux problèmes qui mettent en péril l’intérêt général en santé animale. Il a pour mission d’identifier les agents pathogènes affectant les troupeaux (principalement bovins, ovins, caprins porcins et équins) et provoquant des épizooties (épidémies chez l’animal) ou des zoonoses (maladies animales dont les agents pathogènes sont transmissibles à l’homme).
Il propose de nouvelles alternatives en vaccination. Les équipes du Laboratoire étudient dans ce cadre les agents pathogènes de toute nature responsables de maladies infectieuses comme la fièvre aphteuse, la fièvre catarrhale ovine, la tuberculose bovine, la trichinellose, etc. mais également développent des recherches pour différents vecteurs de maladies (par exemple les tiques). Le Laboratoire œuvre dans le concept « un monde, une seule santé », fournit des données et un appui scientifique et technique aux gestionnaires de risques, notamment dans le cadre de maladies émergentes.
Son intégration au cœur du campus de l’Ecole nationale vétérinaire d’Alfort (EnvA) lui permet de partager avec celle-ci infrastructures, personnel et projets de recherches, et avec la contribution de l’Institut national de la recherche agronomique (Inra) à travers deux unités mixtes de recherche (UMR).
Le Laboratoire est responsable d’une importante activité de référence pour le diagnostic analytique de nombreuses maladies animales, aux niveaux national, européen ou mondial. Il dispose ainsi de 23 mandats de référence, dont 15 mandats nationaux et 8 mandats internationaux.
Quelles perspectives pour les années à venir ?
Afin de conserver son niveau d’excellence, le laboratoire est engagé dans trois défis majeurs : poursuivre la modernisation de son infrastructure, faire face à des émergences et ré-émergences de son domaine d’intervention, intégrer pleinement, dans la chaine de diagnostic-surveillance-maîtrise, les nouvelles technologies qui révolutionnent actuellement l’approche de la santé.
Les changements climatiques planétaires, ainsi que les nouvelles formes de mondialisation des échanges, ont fait émerger des maladies exotiques à fort impact économique en Europe ces dernières années. Ces émergences en infectiologie animale demeurent d’actualité et mobilisent les équipes du Laboratoire (nouveaux variants de virus de la fièvre catarrhale ovine, maladies vectorisées par les tiques, les schistosomes…).
Les « anciennes pathologies » sont toujours une préoccupation pour notre pays et méritent des efforts soutenus du Laboratoire. Un autre défi sera de faire évoluer les méthodes de dépistage, de diagnostic analytique et de contrôle, selon les normes européennes et internationales en vigueur, tout en intégrant les nouvelles technologies d’analyse des génomes et des protéines.
L’analyse fine de l’interaction hôte/agent pathogène, ainsi que le développement de nouvelles méthodes en épidémiologie, permettront au Laboratoire de continuer à lutter contre les maladies animales, émergentes et ré-émergentes, au service du concept « une seule santé » promu par l’organisation mondiale de la santé.


